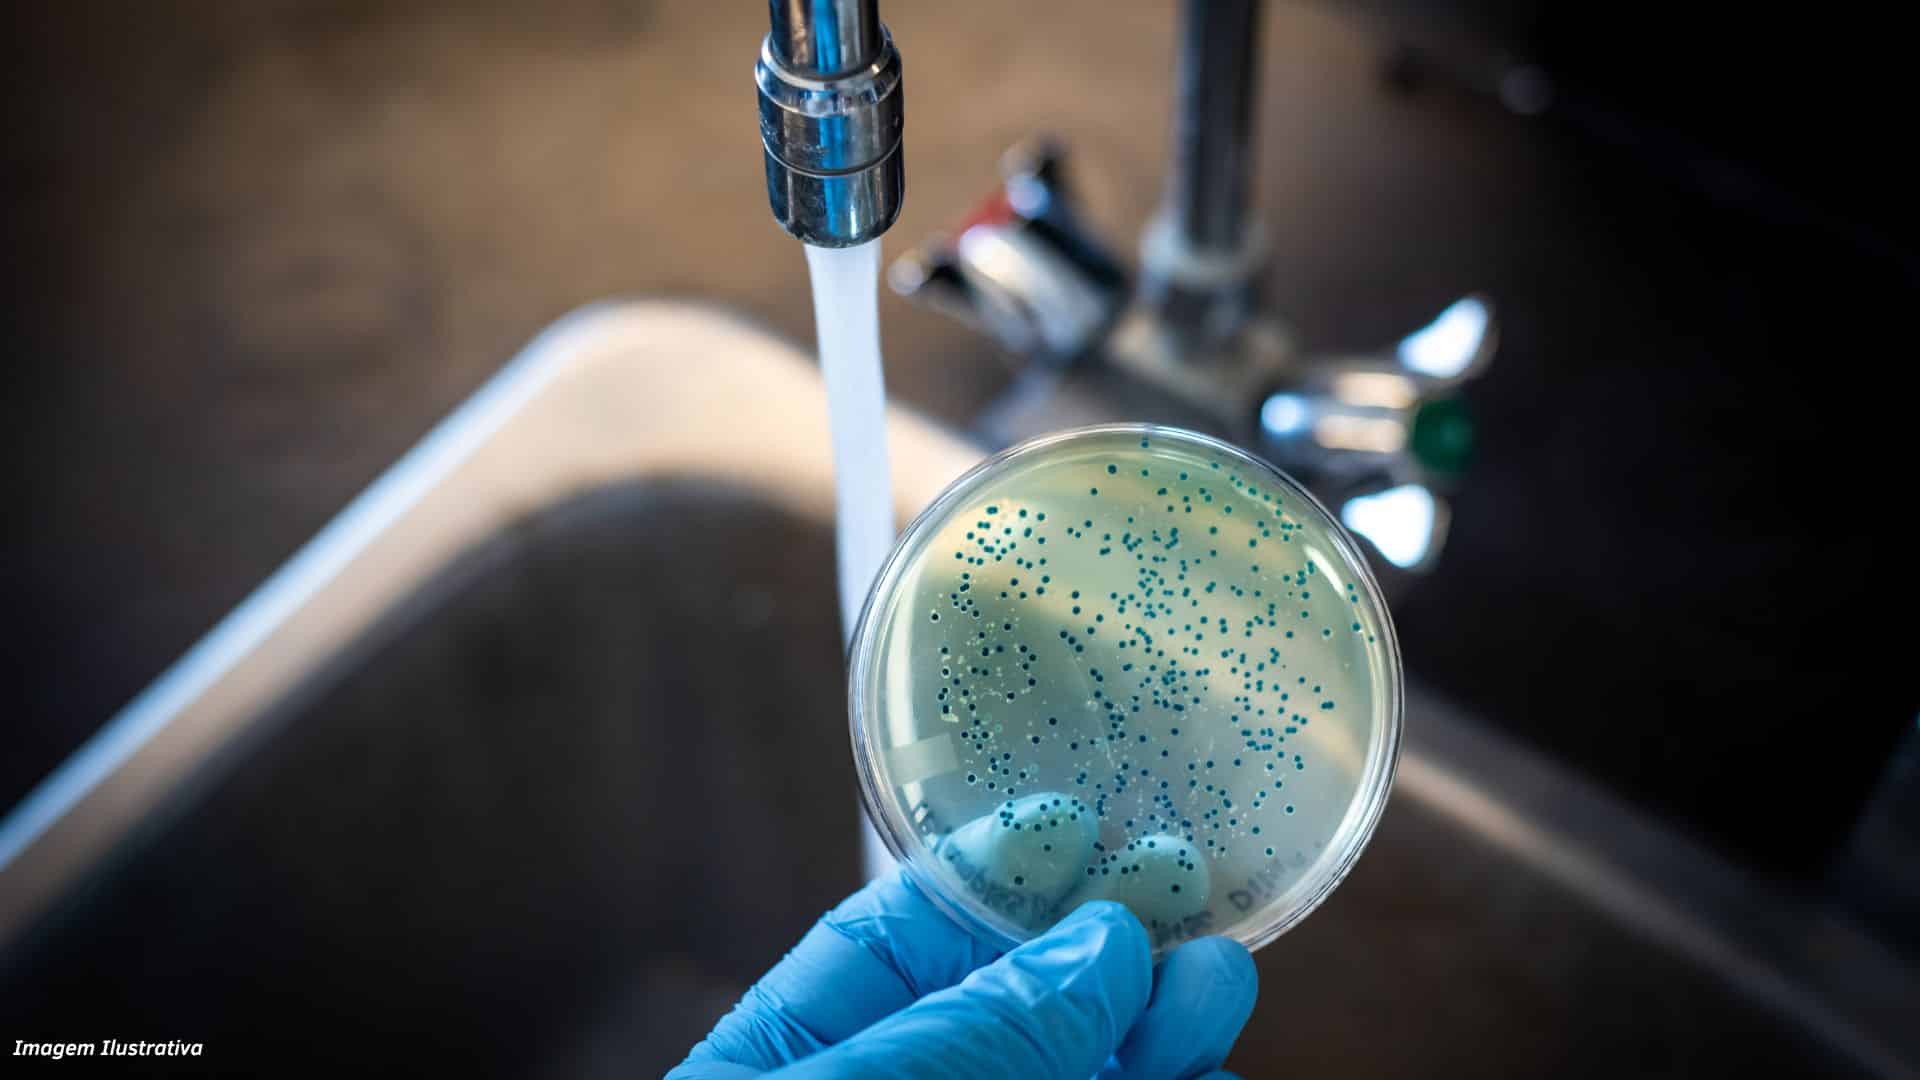

Água Contaminada
Ministério da Justiça instaurou processos a partir de laudos que comprovaram a presença de substâncias nocivas
Mais de 300 empresas e instituições, incluindo concessionárias, associações e condomínios, que distribuíram água contaminada em 1.194 municípios vão responder a processos administrativos instaurados no dia 24, pela Secretaria Nacional de Defesa do Consumidor (Senacon), órgão do Ministério da Justiça.
Em amostras de água distribuídas por essas instituições, foram detectadas substâncias químicas e radiológicas prejudiciais à saúde humana em volume acima do máximo permitido pelo Ministério da Saúde.
Segundo nota do Ministério da Justiça, as empresas têm prazo de 20 dias para prestar os esclarecimentos e apresentar um plano de adequação às regras do governo federal, que determinam os parâmetros de qualidade da água para consumo humano, o chamado padrão de potabilidade.
Em abril, a Senacon apurou notícias veiculadas na imprensa sobre a existência de grandes quantidades de substâncias nocivas na água fornecida em diversos municípios do país. Com apoio de outros órgãos, deu início à perícia de amostras de água.
LEIA TAMBÉM: A CIDADE DOS EUA ONDE ÁGUA CONTAMINADA NÃO PERMITE NEM ESCOVAR DENTES
O Instituto Nacional de Criminalística (INC) da Polícia Federal examinou mais de 3 milhões de resultados de análises laboratoriais, referentes ao controle de qualidade na saída do tratamento ou nos sistemas de distribuição de 8.856 unidades de tratamento de água, localizados em 3.342 municípios.
De acordo com a nota, “o laudo emitido pelo INC destaca que a situação caracteriza ‘um evento perigoso que deve ser gerenciado’, sendo que a ocorrência frequente dessas situações de risco caracteriza exposição a perigo químico”.
O laudo acrescenta que a ingestão de água com a presença desses contaminantes pode estar associada a doenças ou distúrbios, como câncer, doenças na pele, doenças cardiovasculares, metahemoglobinemia em crianças, distúrbios gastrointestinais, dentre outros.
Apesar disso, acrescenta que a população não precisa temer o risco de doenças graves “de forma imediata”, e que medidas adotadas visam a prevenir um cenário em que o consumo continuado dessas substâncias possa trazer riscos à saúde pública.
Caso as empresas tenham um plano de ação para adequar os serviços, poderão aderir a um procedimento de ajustamento de conduta com a Senacon, dentro do prazo de defesa. Caso não atendam à determinação, estão sujeitas a multa diária e eventual condenação.
Fonte: Revista Oeste
ÚLTIMAS NOTÍCIAS: ALEMANHA INVESTE NO CANADÁ COMO PROVEDOR DE ENERGIA
ÚLTIMAS NOTÍCIAS: CIENTISTAS AFIRMAM QUE FERTILIZAR OCEANOS COM FERRO PODE AJUDAR A REMOVER TONELADAS DE DIÓXIDO DE CARBONO POR ANO